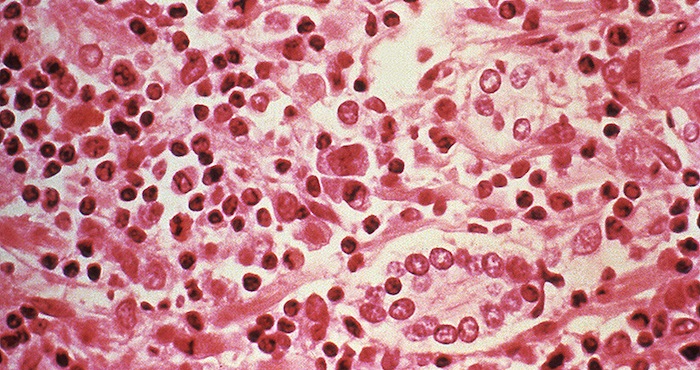

El virus mortal Hanta ha aumentado su incidencia un 81% en Chile. Según especialistas, el aumento de la población de roedores es un factor que ha influido en el alza de casos, ya que estos son los principales portadores de la enfermedad mortal.
Ciudad de México, 16 de noviembre (RT/SinEmbargo).- El virus Hanta se ha cobrado una nueva víctima mortal en Chile. El juez del 3.º Juzgado de Familia de Santiago, Óscar Andrés Saavedra Gianini, ha fallecido este martes por contagio de Hanta, ha informado el Poder Judicial de Chile.
Se cree que el magistrado fallecido, de 38 años, contrajo el virus durante su estancia en la ciudad de Coyhaique, a donde llegó para participar en la 45.ª Convención Nacional de Magistrados celebrada entre el 5 y el 9 de octubre de este año, escribe el diario El Mercurio.
Mientras tanto, permanece en un hospital María Alejandra Ceroni, magistrada del juzgado de Letras del Trabajo de Chillán, que dio positivo en una prueba del virus Hanta tras hacer el mismo viaje que Saavedra Gianini, según medios locales.
El Ministerio de Salud asegura que "la transmisión de la enfermedad de una persona a otra es muy poco probable", enumera los síntomas de la misma –fiebre sobre 38º C, dolores musculares, cefalea, malestar general, decaimiento, náuseas, vómitos y dolor abdominal– y aconseja a quienes han visitado la zona de potencial contagio que consulten de forma inmediata a los servicios locales de Urgencia, recoge El Mercurio.
El diario también apunta que entre enero y el 6 de noviembre del año corriente se han registrado en Chile 80 casos de contagio del virus Hanta, 22 de los cuales han tenido un desenlace fatal. Esto supone un aumento del 81% de los casos, en comparación con el mismo período del año anterior, cuando solo se confirmaron 44 contagios, 8 de los cuales costaron la vida del enfermo.
Dado que los principales portadores del virus son ratones, varios expertos señalan que el aumento registrado deriva del incremento de la reproducción de estos roedores, debido a la abundancia de quila, que es su alimento. Entre otras causas se baraja el aumento de las temperaturas en el país y los incendios forestales que provocan la migración de estos animales a distintas áreas pobladas.
Los primeros casos de contagio del virus Hanta en Chile se remontan a 1995.




